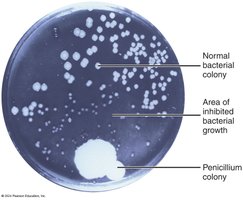
Discovery of penicillin: bacterial inhibition by Penicillium

BackChapter 1: The Microbial World and You – Comprehensive Study Notes
Study Guide - Smart Notes
Tailored notes based on your materials, expanded with key definitions, examples, and context.
The Microbial World and You
Microbes in Our Lives
Microorganisms, or microbes, are organisms too small to be seen with the unaided eye. They play essential roles in the environment, industry, and human health.
Microbes include: Bacteria, Fungi, Protozoa, Microscopic algae, Viruses, and Prions.
Roles of microbes:
Pathogenic (disease-producing) in some cases
Cause food spoilage
Form the basis of aquatic food chains
Decompose organic waste
Incorporate atmospheric nitrogen into organic compounds
Generate oxygen via photosynthesis
Produce chemical products (e.g., ethanol, acetone, vitamins)
Produce fermented foods (e.g., vinegar, cheese, yogurt, bread)
Used in manufacturing (e.g., cellulose) and disease treatment (e.g., insulin)
The Microbiome
The human body hosts trillions of microbial cells, collectively known as the microbiome or microbiota. These microbes are crucial for health and disease prevention.
Normal microbiota: Microbes acquired before birth, colonizing the body indefinitely or transiently (transient microbiota).
Functions:
Maintain health
Prevent growth of pathogens
Train the immune system
Human Microbiome Project: Aimed to determine typical microbiota and their relationship to disease.

Naming and Classifying Microorganisms
Microorganisms are named and classified using a binomial system established by Carolus Linnaeus.
Scientific nomenclature:
Each organism has a genus (capitalized) and a specific epithet (lowercase).
Names are italicized or underlined, Latinized, and used worldwide.
Types of Microorganisms
Microorganisms are classified into several groups based on cellular structure and function.
Bacteria: Prokaryotes, unicellular, peptidoglycan cell walls, divide by binary fission, may have flagella.
Archaea: Prokaryotes, lack peptidoglycan, often live in extreme environments, not known to cause disease.
Fungi: Eukaryotes, chitin cell walls, absorb organic chemicals, yeasts (unicellular), molds/mushrooms (multicellular).
Protozoa: Eukaryotes, absorb/ingest organic chemicals, motile via pseudopods, cilia, or flagella, reproduce sexually/asexually.
Algae: Eukaryotes, cellulose cell walls, photosynthetic, produce oxygen and carbohydrates.
Viruses: Acellular, DNA or RNA core, protein coat, replicate only in living host cells.
Multicellular Animal Parasites: Eukaryotes, helminths (flatworms, roundworms), some microscopic stages.
A Brief History of Microbiology
The First Observations
Early discoveries laid the foundation for microbiology and cell theory.
Robert Hooke (1665): Observed cells, marking the beginning of cell theory.
Anton van Leeuwenhoek (1673–1723): Documented "animalcules" (bacteria, protozoa) using magnifying lenses.
The Debate over Spontaneous Generation
Two hypotheses debated the origin of life:
Spontaneous generation: Life arises from nonliving matter.
Biogenesis: Life arises only from preexisting living cells.

The First Golden Age of Microbiology
Major discoveries between 1857–1914 established the relationship between microbes and disease, immunity, and methods for culturing microorganisms.
Fermentation: Pasteur showed microbes convert sugar to alcohol in absence of air; spoilage bacteria turn wine to vinegar.
Pasteurization: Application of high heat for a short time to kill harmful bacteria in beverages.
Germ Theory of Disease: Lister used antiseptics to prevent surgical infections; Koch established postulates to link microbes to specific diseases.
Vaccination: Jenner inoculated with cowpox to confer immunity to smallpox.
The Second Golden Age of Microbiology
Focus shifted to treating microbial diseases with chemotherapeutic agents and antibiotics.
Paul Ehrlich: Developed salvarsan for syphilis.
Alexander Fleming: Discovered penicillin, the first antibiotic.
Branches and Advances in Microbiology
Bacteriology, Mycology, Parasitology, Immunology, and Virology
Bacteriology: Study of bacteria.
Mycology: Study of fungi.
Parasitology: Study of protozoa and parasitic worms.
Immunology: Study of immunity; vaccines and interferons are used to prevent/treat viral diseases.
Virology: Study of viruses; electron microscopy enabled detailed study.

Molecular Genetics and Genomics
Modern microbiology includes the study of genetic inheritance, molecular biology, and genomics.
Microbial genetics: How microbes inherit traits.
Molecular biology: How genetic information is carried in DNA.
Genomics: Study of an organism’s genes; enables classification and study of microbiomes.
Recombinant DNA: DNA from two sources; enables production of human proteins in microbes.
Microbes and Human Welfare
Recycling Vital Elements
Microbial ecology studies the relationship between microbes and their environment. Microbes recycle elements essential for life.
Bacteria convert carbon, oxygen, nitrogen, sulfur, and phosphorus for use by plants and animals.
Bioremediation and Sewage Treatment
Microbes are used to degrade pollutants and recycle water.
Bacteria degrade organic matter in sewage and detoxify pollutants (e.g., oil, mercury).
Sewage treatment uses microbes to convert organic materials into by-products.
Biotechnology and Recombinant DNA Technology
Microbes are used in practical applications, including food production and genetic engineering.
Recombinant DNA technology enables production of proteins, vaccines, and enzymes.
Gene therapy and agricultural applications (e.g., insect-resistant crops).
Insect Pest Control by Microorganisms
Microbes such as Bacillus thuringiensis are used as alternatives to chemical pesticides.
Produce protein crystals toxic to insects but harmless to animals and plants.
Toxin gene inserted into plants for insect resistance.
Microbes and Human Disease
Normal Microbiota and Resistance
Normal microbiota are microbes present in and on the human body, providing protection and producing growth factors.
Prevent growth of pathogens.
Produce vitamins B and K.
Resistance: Ability of the body to ward off disease; factors include skin, stomach acid, and immune chemicals.
Biofilms
Biofilms are complex masses of microbes attached to surfaces. They can be beneficial or harmful.
Grow on rocks, pipes, teeth, medical implants.
Protect mucous membranes, provide food in aquatic ecosystems.
Can clog pipes, cause infections, and resist antibiotics.

Emerging Infectious Diseases
Emerging infectious diseases (EIDs) are new or increasing in incidence. Factors include evolutionary changes, transportation, and human exposure.
COVID-19: Caused by SARS-CoV-2, declared a pandemic in 2020.
Monkeypox (Mpox): Orthopoxvirus, flu-like illness and rash, human-to-human transmission.
Zika virus: Spread by Aedes mosquitoes, mild disease, severe birth defects if contracted during pregnancy.
H1N1 influenza (swine flu): Pandemic in 2009.
Avian influenza (H5N1): Bird flu, primarily in waterfowl and poultry.
Antibiotic-resistant infections: MRSA, Clostridium difficile, multidrug-resistant tuberculosis.
Ebola virus disease: Ebolavirus, hemorrhagic fever, high mortality, vaccines available.
Marburg virus: Hemorrhagic fever, African fruit bats as reservoir.


Summary Table: Types of Microorganisms
Type | Cell Type | Cell Wall | Reproduction | Energy Source |
|---|---|---|---|---|
Bacteria | Prokaryote | Peptidoglycan | Binary fission | Organic/inorganic chemicals, photosynthesis |
Archaea | Prokaryote | No peptidoglycan | Binary fission | Varied (often extreme environments) |
Fungi | Eukaryote | Chitin | Sexual/asexual | Absorb organic chemicals |
Protozoa | Eukaryote | None | Sexual/asexual | Absorb/ingest organic chemicals |
Algae | Eukaryote | Cellulose | Sexual/asexual | Photosynthesis |
Viruses | Acellular | Protein coat (sometimes lipid envelope) | Host-dependent | Host-dependent |
Helminths | Eukaryote | None | Sexual/asexual | Parasitic |
Key Equations and Concepts
Pasteurization: Application of heat to kill microbes without evaporating alcohol.
Binary fission: Bacterial cell division process.
Microbial resistance: Ability of microbes to withstand antimicrobial drugs.
Equation for microbial population growth:
Where = final number of cells, = initial number of cells, = number of generations.
Additional info: This equation is fundamental for understanding microbial growth in laboratory and environmental settings.